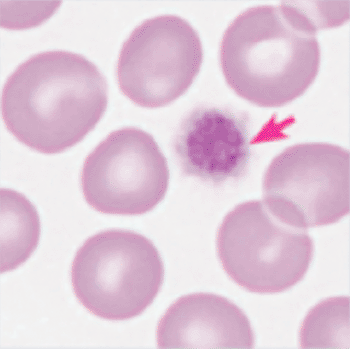
Image: Giant platelet in a blood film (Photo courtesy of Sysmex).

Critical Care

In Other News
Google Contact Lens Could Monitor Glucose Levels
IMRT Radiotherapy for Head and Neck Cancer May Be Superior to Standard Radiation
Point-of-Care Hemoglobin Testing Compared with Laboratory Analyzer
Ultra-Light Nasal Pillows Improve Users’ Sleep
Fast Food Not Main Culprit in Rising Childhood Obesity Rates
Radiotherapy Advances Result in More Targeted Treatments, Less Harm to Healthy Tissue
Untreatable Tuberculosis Spreading in South Africa
Health Care Workers Carry Diarrhea Spores on Their Hands
Cardiologists Urged to Lessen Patient Radiation Exposure
The Longer the Colonoscopy Takes, the Better
Patients Safety Movement Doubles MedTech Commitments
Rising Hygiene Standards Linked to Incidence of Diabetes
Power Efficient Bluetooth Oximeter Facilitates Patient Monitoring
Saving Back Pain Patients from X-Rays with Electrogoniometer Technology
Closed System Drug Transfer Device Prevents Contamination
Clearance System Removes Mucus from the Airways
Serum Cholesterol Levels Linked to Cerebral Amyloidosis
Novel Brain-Stimulation Device Treats Migraines
Daily Aspirin Risks May Outweigh Benefits
High Blood Pressure May Be More Dangerous for Women
Electromagnetic Field Generator Reduces Postoperative Pain
Pharmacists Reduce Errors in In-Hospital Medications
New Technologies Help Prevent Nosocomial Infections
HospiMedica Critical Care channel provides timely reporting on emergency medicine, intensive care, anesthesia, neonatal care, patient monitoring, respiratory care, infection control, and more hospital related subjects.







